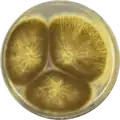
Aspergillus indologenus growing on CYA plate

Aspergillus indologenus
| Aspergillus indologenus | |
|---|---|
| Scientific classification | |
| Kingdom: | Fungi |
| Division: | Ascomycota |
| Class: | Eurotiomycetes |
| Order: | Eurotiales |
| Family: | Aspergillaceae |
| Genus: | Aspergillus |
| Species: | A. indologenus
|
| Binomial name | |
| Aspergillus indologenus Frisvad, Varga & Samson (2011)[1]
| |
Aspergillus indologenus is a species of fungus in the genus Aspergillus. It belongs to the group of black Aspergilli which are important industrial workhorses.[2][3][4] A. indologenus belongs to the Nigri section. The species was first described in 2011.[1] It was isolated from soil in India and found to produce insecticidal compounds okaramins A, B, H, and two types of indol-alkaloids which have not been structure elucidated.[1]
The genome of A. indologenus was sequenced and published in 2014 as part of the Aspergillus whole-genome sequencing project – a project dedicated to performing whole-genome sequencing of all members of the genus Aspergillus.[5] The genome assembly size was 38.59 Mbp.[5]
Growth and morphology
Aspergillus indologenus has been cultivated on both Czapek yeast extract agar (CYA) plates and Malt Extract Agar Oxoid® (MEAOX) plates. The growth morphology of the colonies can be seen in the pictures below.
-
Aspergillus indologenus growing on CYA plate
Aspergillus indologenus growing on CYA plate -
 Aspergillus indologenus growing on MEAOX plate
Aspergillus indologenus growing on MEAOX plate
References
- ^ a b c Varga J, Frisvad JC, Kocsubé S, Brankovics B, Tóth B, Szigeti G, Samson RA (June 2011). "New and revisited species in Aspergillus section Nigri". Studies in Mycology. 69 (1): 1–17. doi:10.3114/sim.2011.69.01. PMC 3161757. PMID 21892239.
- ^ Pel HJ, de Winde JH, Archer DB, Dyer PS, Hofmann G, Schaap PJ, et al. (February 2007). "Genome sequencing and analysis of the versatile cell factory Aspergillus niger CBS 513.88". Nature Biotechnology. 25 (2): 221–31. doi:10.1038/nbt1282. hdl:1887/67447. PMID 17259976.
- ^ Goldberg I, Rokem JS, Pines O (2006). "Organic acids: old metabolites, new themes". Journal of Chemical Technology & Biotechnology. 81 (10): 1601–1611. doi:10.1002/jctb.1590.
- ^ Pariza MW, Foster EM (May 1983). "Determining the Safety of Enzymes Used in Food Processing". Journal of Food Protection. 46 (5): 453–468. doi:10.4315/0362-028x-46.5.453. PMID 30913657.
- ^ a b "Home - Aspergillus indologenus CBS 114.80 v1.0". genome.jgi.doe.gov.